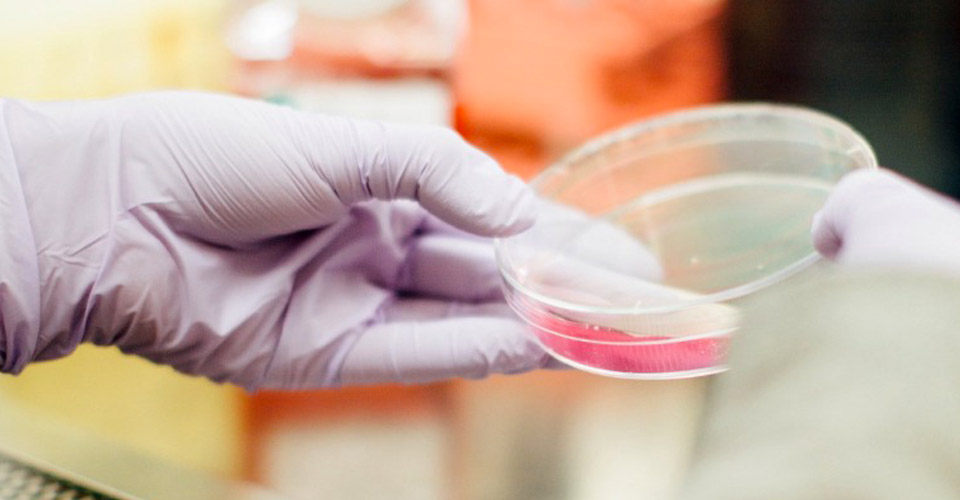
Lab Image

Lynparza (olaparib) is the first PARP inhibitor approved to treat breast cancer, and the first medicine ever for metastatic breast cancer who have a “BRCA” gene mutation.
Blog
-
January 18, 2018Read more »
-
January 14, 2018Read more »
A new study found that cabozantinib (Cabometyx) was more effective than everolimus in advanced renal cell carcinoma and bone metastases.

-
January 07, 2018Read more »
Pembrolizumab showed positive results in heavily pretreated, PD-L1–positive advanced esophageal carcinoma.

-
Read more »
Specific strains of intestinal bacteria can improve the response rate to immunotherapy for patients being treated for advanced melanoma.

-
December 30, 2017Read more »
Eight important updates in lung cancer.

-
December 21, 2017Read more »
Darzalex (daratumumab) combination under review as first-line option.

-
Read more »
Immunotherapy nivolumab has been linked to HIV reservoir decrease in a lung cancer patient.

-
December 07, 2017Read more »
In a pilot study immunotherapy proved active in some patients with metastatic, trastuzumab (Herceptin)-resistant HER2-positive breast cancer.

-
December 02, 2017Read more »
Researchers are suggesting that metastatic tumours in the lung can be successfully eradicated using cryotherapy – literally turning the masses into ice balls that are then resorbed by the body.

-
November 28, 2017Read more »
Mavenclad (cladribine) has become the multiple sclerosis therapy of choice for 1 in 5 neurologists in Germany and the UK. Meanwhile, many European neurologists wait for Ocrevus (ocrelizumab).

-
June 15, 2017Read more »
With recent drops in new HIV diagnoses being linked to buying PrEP through online buyers clubs, the addition of PrEP to the WHO's essential medicine list, and the recent approval of generic PrEP in the US - here’s what you need to know.

-
Read more »
PTC Therapeutics announce the launch of Emflaza for the treatment of Duchenne muscular dystrophy (DMD) within the coming weeks, with an expected net price of $35,000.

-
December 08, 2015Read more »
On Sunday former US president and Nobel Peace Prize laureate proclaimed to a Sunday school class that he is cancer-free.

-
Read more »
Impressive results have been published last week regarding two new immunotherapies.

Experts in novel medicines
Experts in novel medicines

